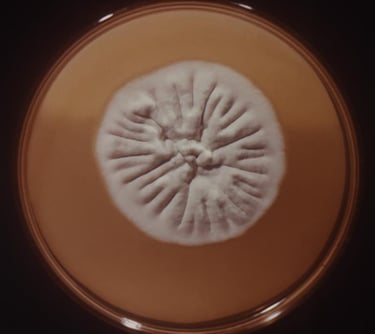
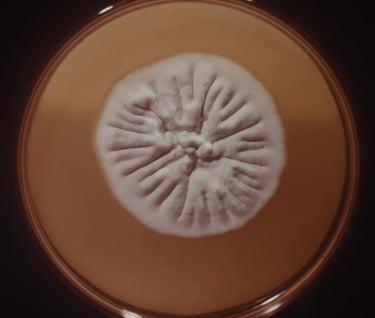

MICOLOGIA
🍄Estudia los hongos: aliados invisibles y a veces enemigos ocultos.
La micología se dedica al estudio de los hongos: organismos tan versátiles que pueden ser curativos, deliciosos… o peligrosamente tóxicos.
Investiga su morfología, reproducción, metabolismo y su relación con otros seres vivos. Levaduras, mohos y setas no solo forman parte de nuestra dieta y medicinas, también juegan un rol crucial en la descomposición y el equilibrio ecológico.




Explora la micología
🍄 Bienvenido al fascinante mundo de los hongos
¿Sabías que algunos organismos pueden curarte, alimentarte o enfermarte… y todos pertenecen al reino Fungi? En MicrobioOnline, te abrimos la puerta al mundo de los hongos, seres tan diversos como esenciales para la vida en la Tierra.
La micología no solo se trata de setas comestibles o mohos en el pan: es una rama de la microbiología que estudia organismos capaces de descomponer, fermentar, infectar o incluso salvar vidas gracias a sus propiedades medicinales.
Tanto si estudias microbiología, enseñas biociencias o simplemente sientes curiosidad por lo invisible, esta sección está hecha para ti.
🍄 ¿Qué encontrarás en Micología?
🧬 Clasificación de los hongos: conoce las principales clases de hongos microscópicos y macroscópicos: levaduras, mohos y hongos filamentosos.
🔬 Estructura y fisiología: explora cómo están formados los hongos, sus tipos celulares, reproducción (sexual y asexual) y metabolismo.
⚠️ Micosis humanas: identifica las enfermedades causadas por hongos, desde infecciones superficiales hasta sistémicas.
🦠 Hongos patógenos y oportunistas: diferencia entre hongos que atacan directamente y los que afectan a personas inmunocomprometidas.
💊 Aplicaciones médicas e industriales: descubre el papel de los hongos en la producción de antibióticos, alimentos fermentados y biotecnología.
🌱 Importancia ecológica: comprende cómo los hongos contribuyen al reciclaje de materia orgánica y a la simbiosis con plantas.
🌟 Adéntrate en un reino misterioso, vital y lleno de sorpresas.


Candida albicans


Microsporum

Trichophyton rubrum
Conocimiento
Difundimos ciencia en microbiología y laboratorio clínico.
Recursos
Contacto
info@microbioonline.com
© 2025. All rights reserved.